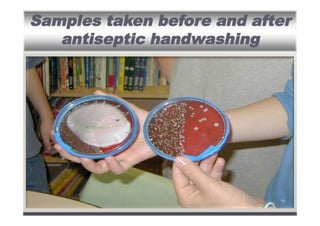
Samples taken before and after
antiseptic handwashing

٣٤

The document outlines the importance of infection control in healthcare settings to ensure patient, staff, and visitor safety. It emphasizes the rise in healthcare-associated infections (HAIs) and the necessity of coordinated infection control programs that include hand hygiene, use of personal protective equipment (PPE), and effective organizational policies. The goal is to reduce infection risks through comprehensive strategies that involve all healthcare personnel in preventive measures.